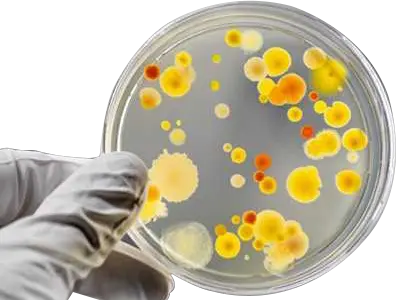
生物学研究室

pHストリップ電極 /
使い捨てpHセンサー
Humming ProbeUH1
正確で、キャリブレーション不要ですぐに使用可能
極小サンプル量(10~20μL)で測定
サンプルのクロスコンタミネーションを避けるため、使い捨てセンサーを採用
精度はpH±0.1まで達成可能
各ストリップ電極には温度検出素子が内蔵されています。
Humming Probe
pH測定システムはキャリブレーション不要です。
特許取得済みの水素イオン
交換フィルム設計
特許取得済みの水素イオン吸着膜により、サンプル中の水素イオンを選択的に通過させるだけでなく、サンプル中の他のマトリックスが電極表面に吸着して不活性化されるのを防ぎ、サンプル処理手順を簡素化します。さらに、ネルンスト式におけるEk'値に影響を与える表面交換可能な水素イオン含有量は、この水素イオン吸着膜の設計によって正確に制御できます。

自動生産技術
自動生産機は、自動生産モデルを通じて、pHストリップ電極の生産安定性をCV値3〜5%で達成します。また、温度感知部品組み立て機など、さまざまな製造プロセス要件に合わせて多種類の自動機械を開発し、生産の安定性と一貫した品質を向上させています。

工場を出る前のキャリブレーション
各ストリップ電極は、工場出荷前にトレーサビリティ標準を使用して較正および検証されているため、バイアルから取り出してすぐにpHを直接テストすることができます。

独立した温度検出素子の装備
各ストリップ電極には独立した小容量温度感知素子が組み込まれており、サンプル温度が10〜40℃の範囲内であれば、サンプル量が少なくても自動温度補正(ATC)機能が働き、分解能は±0.01pHに達します。

Humming Probe pHストリップ電極 UH1は、校正が不要であることに加えて、
サンプル量は少量で使い捨てセンサーが特徴です。

1滴の測定が可能で、サンプル要件を
10μlに減らすことができます。
血液、唾液、脳脊髄液、組織液などの生体試料は、大量にサンプリングすることができません。通常、このような少量のサンプルでテストを行うためには、高価な超小型ガラス電極が必要でした。しかし、UH1は、サンプルを滴下するか浸漬することで、完璧な測定ソリューションを提供します。

体液(発汗)検出

発酵プロセス制御
使い捨てタイプのpHセンサーで、
さまざまな分野での用途を広げます。
新品のpHストリップ電極は、使用のたびにバイアルから取り出してすぐに使用でき、テスト後に時間のかかるクリーニングやメンテナンスは必要ありません。粘性のあるサンプルや吸着しやすいサンプル、またはさまざまな特殊処理との組み合わせにより、従来のガラス電極の限界を超えて、より多くの用途に対応できるようになります。

滅菌や不活性化などの特別な
治療が可能

クリーンアップが難しい粘性
サンプルの
テスト

Humming Probe pH測定システムの精度について
測定データをNIST標準pH緩衝値と比較し、線形回帰方程式に従って相関係数を取得します。
| NIST 標準 pH バッファー | 2 | 7 | 12 |
|---|---|---|---|
| サンプリング数 | 10 | 10 | 10 |
| 平均値(pH) | 1.99 | 6.99 | 11.97 |
| SD(pH) | 0.01 | 0.02 | 0.03 |
| CV(%) | 0.75% | 0.35% | 0.26% |
| 精度範囲(pH) | 0.05 | 0.08 | 0.09 |
UH1の測定データとNISTの
pH緩衝液の値を比較します。
| 測定範囲 | pH 0~14* |
|---|---|
| 傾き | 1.0029 |
| 切片 | -0.0521 |
| 相関係数(r) | 0.9999 |
※ pH 0溶液は1.0M HCl溶液です。
※ pH 14溶液は1.0M NaOH溶液です。

pHと測定電位の直線性

繰り返し再現性

さまざまなサンプルの測定
(ガラスpH計との比較)

Humming Probe pH測定システムの使用方法について
すべての製品は、工場出荷前にNISTトレーサビリティ基準に基づいて校正および検査され、各バッチの校正情報はバイアルのキャップにQRコードとして印刷されています。初めてpHストリップ電極を使用する際には、QRコードをスキャンして技術パラメータをメーターに読み込むことで、pH測定を直接実行できます。従来のガラス電極製品とは異なり、Humming Probeは非常に便利で、複雑な校正手順を必要としません。

バイアルからpHストリップ電極を取り出します。

測定方法1
少量のサンプル溶液をストリップに直接滴下します。

測定方法2
ビーカーセルに直接浸漬します。
Humming Probe pH測定システムの有効な活用シーン
生物学研究室
培地や緩衝液のpH値は通常、0.1pH以内に調整されます。UltraE社のHumming Probeは、細胞や細菌が適切な環境で増殖していることを確認するために、培地に直接挿入し、リアルタイムでpH値を観察することができます。
屋外立入検査
従来の環境汚染監視では、サンプルを採取し、実験室で分析する方法が一般的で、直接の現場検査はほとんど行われていません。そのため、汚染問題の発見に時間がかかることがよくあります。本システムでは、校正溶液を持ち運ぶ必要がなく、pHメーターとpHストリップ電極のみで直接検査を実施できます。これにより、試験結果を迅速に取得でき、測定時間を大幅に短縮し、汚染の程度を即座に把握することが可能になります。

バイオメディカル検出分野
血液、尿、脂質液などの生物医学サンプルは量が少ないため、従来のpHメーターの代わりに比色法が一般的に使用されています。しかし、比色法では正確なデータを得るのが難しいことがよくあります。これに対し、UltraE社のHumming Probeは、わずか1〜20μLのサンプルでテストを実行でき、より高精度な測定が可能です。

農業分野
土壌の酸性度とアルカリ度(pH)は、作物を植える際の重要な要素です。本システムは、湿った土壌のpHを直接測定できるため、植物の成長管理や土壌改良に役立ちます。土壌そのものだけでなく、水溶性の培地にも対応しており、幅広い用途で活用できます。

食品・飲料加工業界
食品の製造過程において、pH値は味や鮮度、保存期間に影響を与えます。特許取得済みのイオン膜とHumming Probe pHストリップ電極の設計により、通常は前処理が必要な肉、魚、ジャム、シーフード、牛乳、チーズ、ヨーグルト、乳製品、ソース、お茶などのサンプルでも、正確なpH測定が可能です。

合成実験室
有機合成、非有機合成、高分子合成など、どのような実験を行う場合でも、異なる反応条件下で各相のpHを適切に管理することが重要です。本システムは、小さなサンプルに直接浸漬して、さまざまな段階で正確なpH値を測定できます。また、電極への不純物の付着やシステムへの汚染物質の混入も防ぐことができます。

仕 様

| モデル | UH1 |
|---|---|
| 測定範囲 | pH 0~14 |
| 精度 | ±0.1pH |
| 最小サンプル量 | 10~20μL |
| サンプル温度 | 10~40℃(<10℃または>40℃は警告を表示します) |
| 寸法 | W12.6×L60×T1mm(End width:2mm) |
| 数量 | 25個入x2瓶/箱 |
※ pHストリップ電極は、常にキャップをしてバイアルに保管し、使用時のみ取り出す必要があります。1瓶には電極が25本入っており、1箱には2瓶が入っています。
関連商品
電気化学セルスタンド【CS100】
電気化学実験用に設計されたマグネットスターラーです。攪拌速度制御と温度制御とカウントダウンタイマー機能があります。独自に設計したホルダーは3電極系の測定や印刷電極の固定も可能です。







の